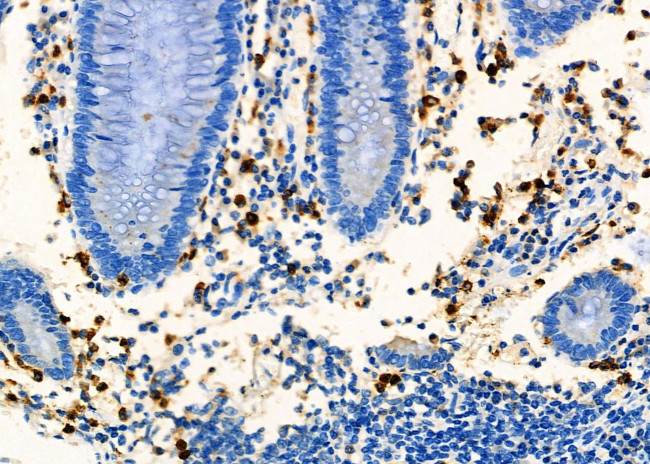
CD8 Antibody in Immunohistochemistry (Paraffin) (IHC (P))

Search
Invitrogen
CD8 Polyclonal Antibody
{{$productOrderCtrl.translations['antibody.pdp.commerceCard.promotion.promotions']}}
{{$productOrderCtrl.translations['antibody.pdp.commerceCard.promotion.viewpromo']}}
{{$productOrderCtrl.translations['antibody.pdp.commerceCard.promotion.promocode']}}: {{promo.promoCode}} {{promo.promoTitle}} {{promo.promoDescription}}. {{$productOrderCtrl.translations['antibody.pdp.commerceCard.promotion.learnmore']}}
图: 1 / 4
CD8 Antibody (PA5-114991) in IHC (P)




Please note: We are reviewing Western blot images included in the antibody testing data in our catalog, including those provided by third parties. Unless expressly labeled or annotated as “raw-unedited”, Western blot images included in the antibody testing data in our catalog may have been edited, optimized or otherwise adjusted for presentation.
产品信息
PA5-114991
种属反应
宿主/亚型
分类
类型
抗原
偶联物
形式
浓度
规格
纯化类型
保存液
内含物
保存条件
运输条件
RRID
产品详细信息
Antibody detects endogenous levels of total CD8.
靶标信息
CD8, also known as cluster of differentiation 8, is a type I transmembrane glycoprotein of the immunoglobulin family that plays a crucial role in T cell differentiation, activation, and signal transduction. It is expressed as either a heterodimer (CD8 alpha beta) or a homodimer (CD8 alpha alpha). The CD8 alpha beta form is predominantly found on the majority of thymocytes and a subpopulation of mature alpha beta TCR T cells, while the CD8 alpha alpha form is expressed on gamma delta TCR T cells, a subset of intestinal intraepithelial lymphocytes (IELs), and dendritic cells. CD8 functions as a co-receptor for major histocompatibility complex class I (MHC-I) molecules, working alongside the T cell receptor (TCR). The CD8 alpha chain is essential for binding to MHC-I. CD8 is also expressed on a subset of T cells, NK cells, monocytes, and dendritic cells as disulfide-linked homodimers of CD8 alpha. Upon ligation of MHC-I/peptide complexes presented by antigen-presenting cells (APCs), CD8 recruits lymphocyte-specific protein tyrosine kinase (Lck), leading to lymphokine production, increased motility, and activation of cytotoxic T lymphocytes (CTLs). Activated CTLs are vital for clearing pathogens and tumor cells. The differentiation of naive CD8+ T cells into CTLs is strongly enhanced by cytokines such as IL-2, IL-12, and TGF-beta1. Through its interactions with MHC-I and association with protein tyrosine kinase p56lck, CD8 plays a significant role in T cell development and the activation of mature T cells.
仅用于科研。不用于诊断过程。未经明确授权不得转售。
篇参考文献 (0)
生物信息学
蛋白别名: CD8 antigen 32 kDa chain; CD8 antigen 37 kDa chain; CD8 antigen alpha-chain; CD8 antigen beta-chain; CD8 antigen, alpha chain; CD8 antigen, alpha-chain; CD8 antigen, beta chain; CD8 antigen, beta-chain; CD8a; CD8alpha; CD8b; CD8beta; fCD8; Leu-2; leu-2a; Lymphocyte antigen 3; Lyt-2.1 lymphocyte differentiation antigen (AA at 100); OX-8 membrane antigen; T-cell membrane glycoprotein Ly-3; T-cell surface glycoprotein CD8 alpha chain; T-cell surface glycoprotein CD8 beta chain; T-cell surface glycoprotein Lyt-2; T-cell surface glycoprotein Lyt-3; T-lymphocyte differentiation antigen T8/Leu-2
基因别名: BB154331; CD8A; CD8B; CD8B1; Ly-2; Ly-3; Ly-35; Ly-B; Ly-C; Lyt-2; Lyt-3; Lyt2; Lyt3; MAL
UniProt ID: (Mouse) P01731, (Rat) P07725, (Rat) P05541, (Mouse) P10300
Entrez Gene ID: (Mouse) 12525, (Rat) 24930, (Rat) 24931, (Mouse) 12526